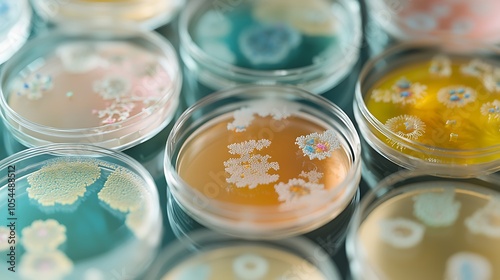

Download sample
File Details
Published: 2024-10-29 22:05:52.188874 Category: Food Type: Illustration Model release: NoShare
A collection of Petri dishes with growing bacterial cultures. Investigating microbial life through observation.
Contributor: NOORULHASSAN
ID : 1054488512
